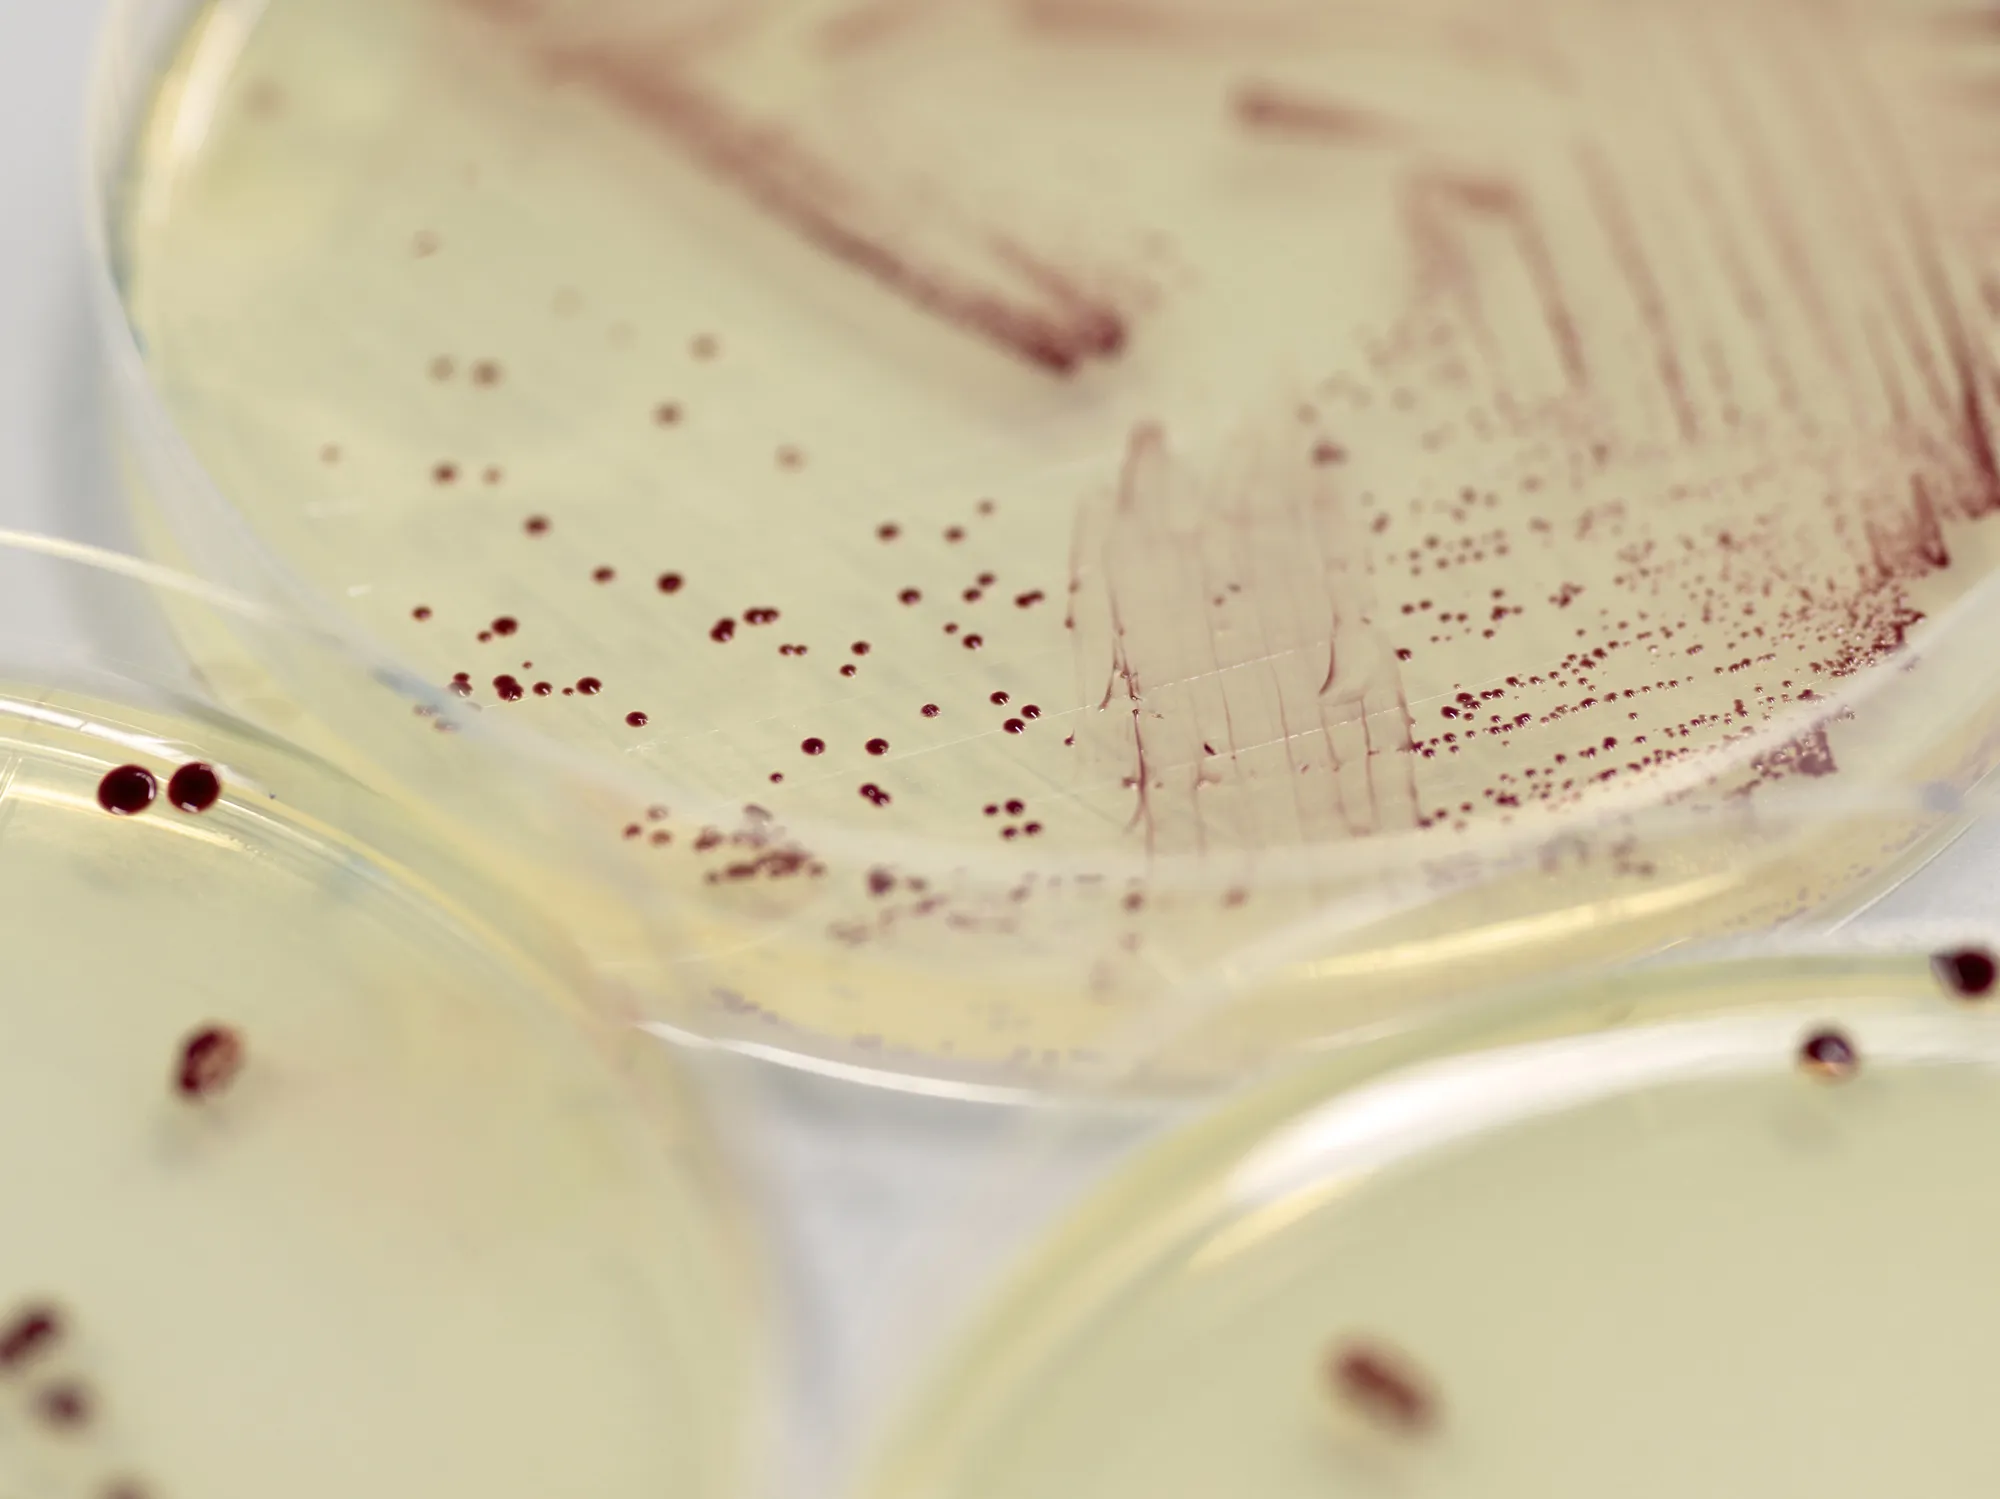
Marine purple photosynthetic bacteria

Turning air into resources
地球の大半を覆う海水には光合成し、空気を吸収して増殖する微生物が生息しています。Symbiobeのテクノロジーが可能にするのは、その光合成生物がもつ天然の力を借りて空気を資源化し、人の生活に欠かせない様々なプロダクトを創造すること。この自然との共創は、地球と人類のこれからの共生を考えるための大切な取り組みです。

微生物の力が空気を資源化する
私たちが力を借りている、赤く美しい躯体をもつ微生物「海洋性紅色(こうしょく)光合成細菌」は、世界中のどこの海水中にも生息する、とてもありふれた存在です。しかし、ある特徴を有しています。それは生命の増殖、自生に二酸化炭素または窒素が必要だということ。太陽の光を受けると光合成する海洋性紅色光合成細菌は、光合成の際に二酸化炭素を、加えて窒素を生物躯体に固定させることができ、空気と海水中のミネラルを養分に増殖していきます。
ものづくりと温室効果ガスの固定を両立
この微生物の光合成、空気の固定によって様々な有機化合物、代謝産物が合成されます。それを次世代の農業向け窒素肥料や、化石燃料由来の素材の代替となる環境にやさしい革新的な繊維などとして活用できること、そして気候変動の原因のひとつである温室効果ガスを資源へと変換させられる可能性を見出しました。将来的な私たちの目標としてあるのは、工場や飛行機などから排出される大量の二酸化炭素のゼロ化です。

資源を輸入せず、何もないところから生み出す
「20世紀型ものづくり」では原油などをつくる炭素資源、肥料や工業原料などをつくる窒素資源が多くもちいられてきました。これに対して、特に資源が乏しい日本は大半を輸入でまかなっているため、海外情勢の変化による不安定性も課題に挙げられます。海外に依存せず、何もないところから資源を生み出し、ものづくりをすることができれば。この課題に対する発想もSymbiobeがもつテクノロジーの出発点となっています。
直線的な資源消費から資源循環へ
現在まで取り残されてきた「気候変動」や「資源不足」といった課題の解決は人類共通のミッションであり、いま、地球と人とのより良い共生を考え直し、志すために皆が行動を起こすべき時代を迎えています。これから先、営みを続けていくために必要となってくるのが、直線的な資源消費から資源循環へのシフトを可能にする、私たちSymbiobeのテクノロジーだと考えています。

アカデミアの指針であり、Symbiobeの動力
Symbiobeの背景には、弊社のファウンダーであり、京都大学大学院の教授である沼田圭司が取り組んできた研究テーマ「生物素材の学理にもとづいた、循環型材料の創出」があります。
沼田は東京工業大学の博士課程の際、生物高分子(=バイオポリマー)の結晶構造解析という分野で学位を取得。その後、研究員並びにチームリーダーを務めていた理化学研究所では、「解析」を超え、クモの糸をはじめとする自然界の生物がもつタンパク質・アミノ酸をつなげることで多様な物性を体現できること、それをもとにプロダクトをつくり出せる技術に沼田は魅力を感じ、現在も継続的な研究に取り組んでいます。
「従来の食料やエネルギー生産と競合せず、環境負荷も少なく、地球にも人にもやさしい材料と全く新しい循環の仕組みを作りたい」。この沼田の想いと研究に対するモチベーションが、沼田が現在主導している京都大学のアカデミアの指針となるのと同時に、Symbiobeを駆動させているのです。
Numata LaboratoryOur advertisement feature in the online version of Nature
Focal Point on Building a Carbon-Neutral Society
2024年7月11日付で、国際的な総合科学雑誌Natureオンライン版に、沼田の研究・成果等を紹介する記事広告特集「Focal Point on Building a Carbon-Neutral Society」が掲載されました。(言語=英語)
